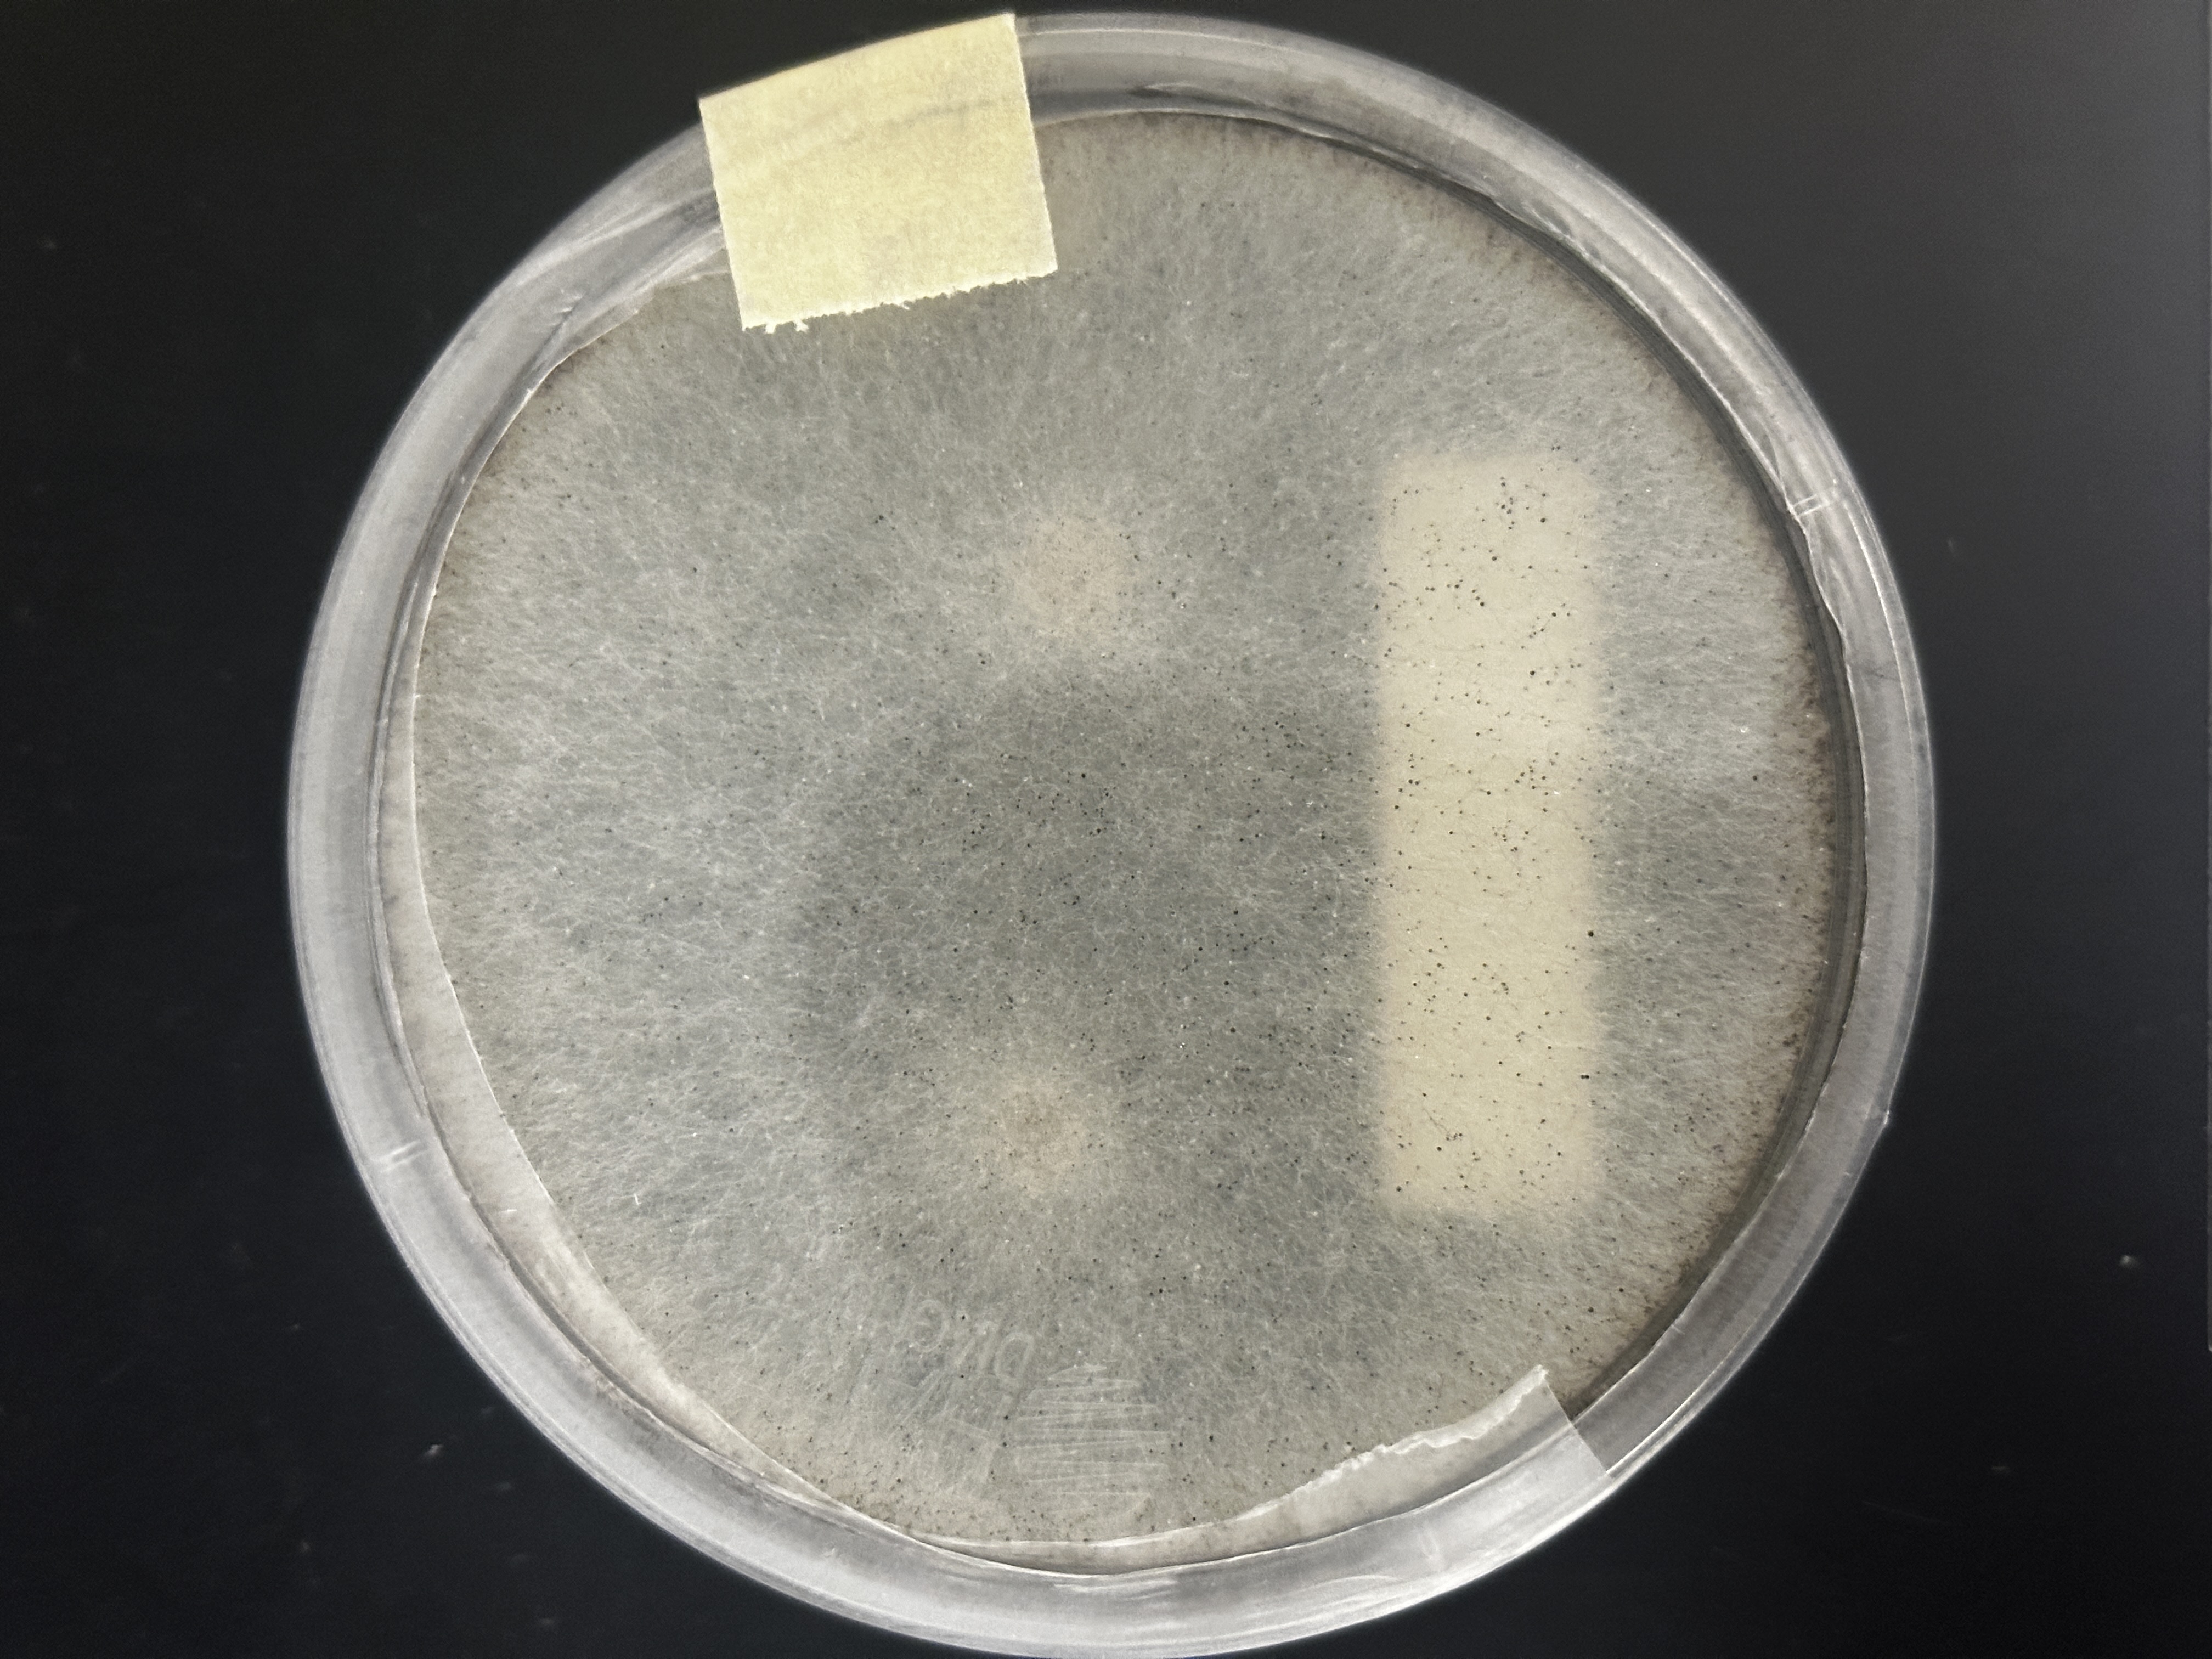
<p>Identify (Domain, Kingdom, Clade)</p>
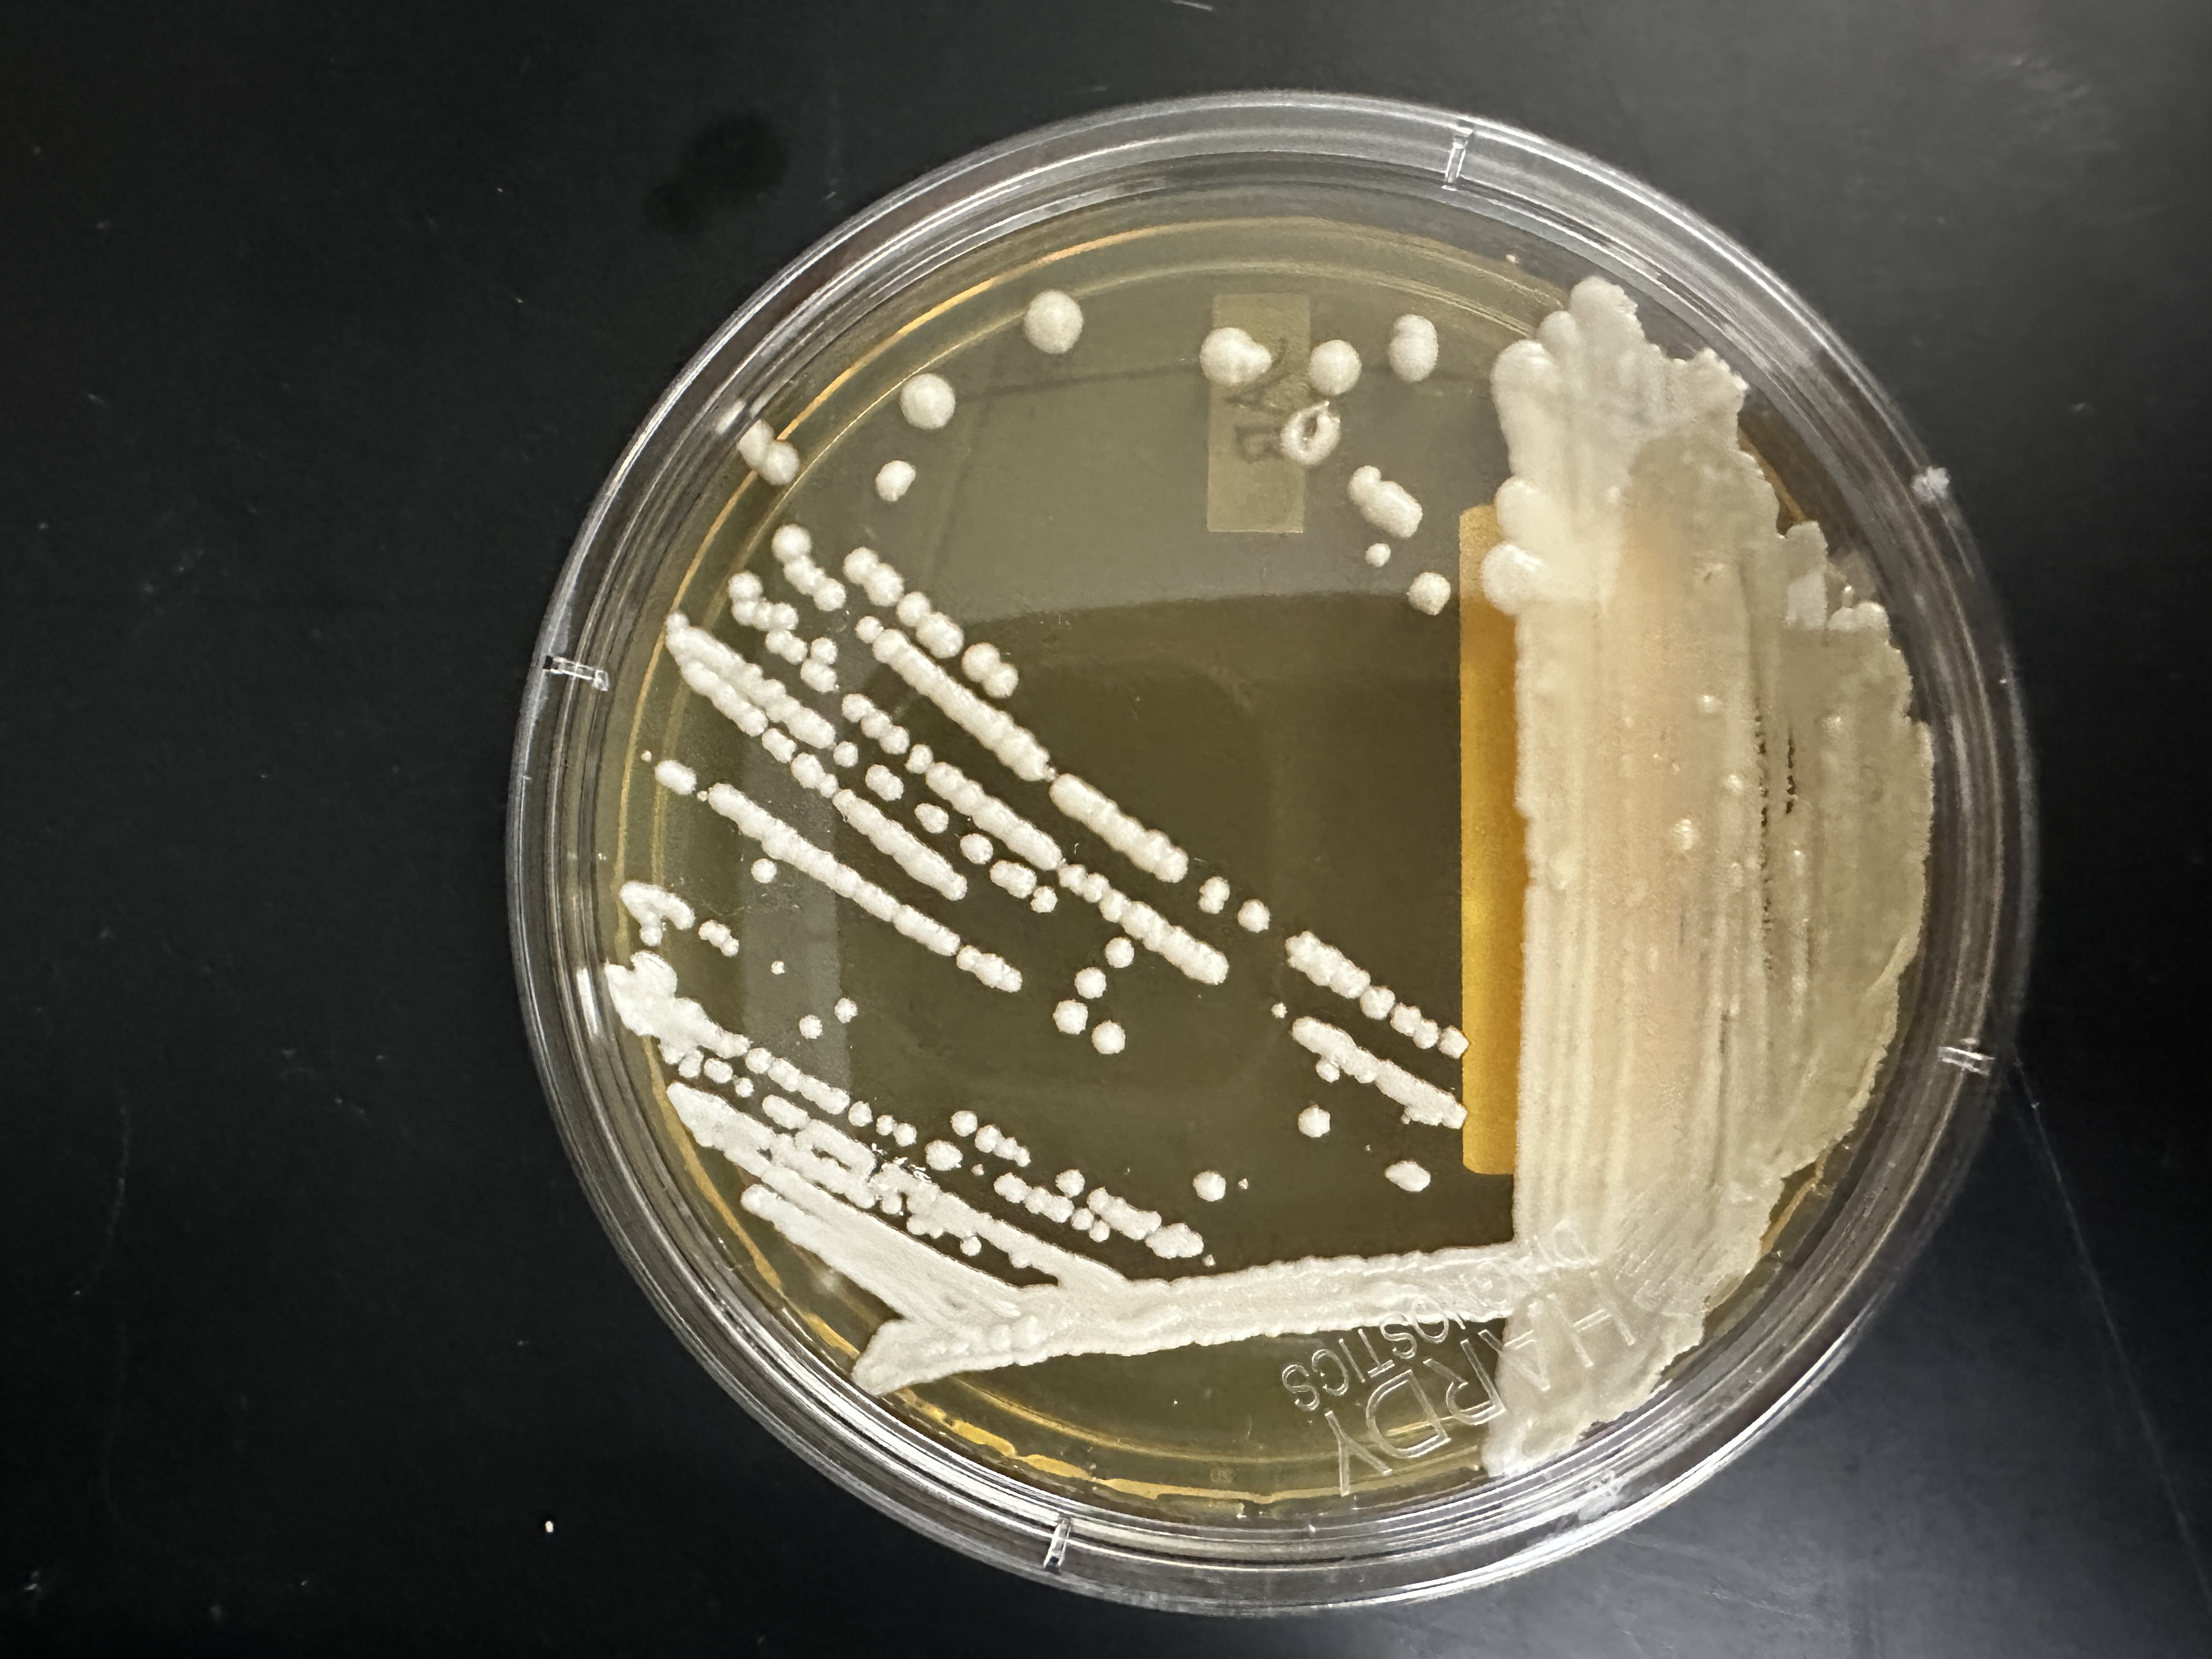
<p>Identify (Domain, Kingdom, Clade)</p>
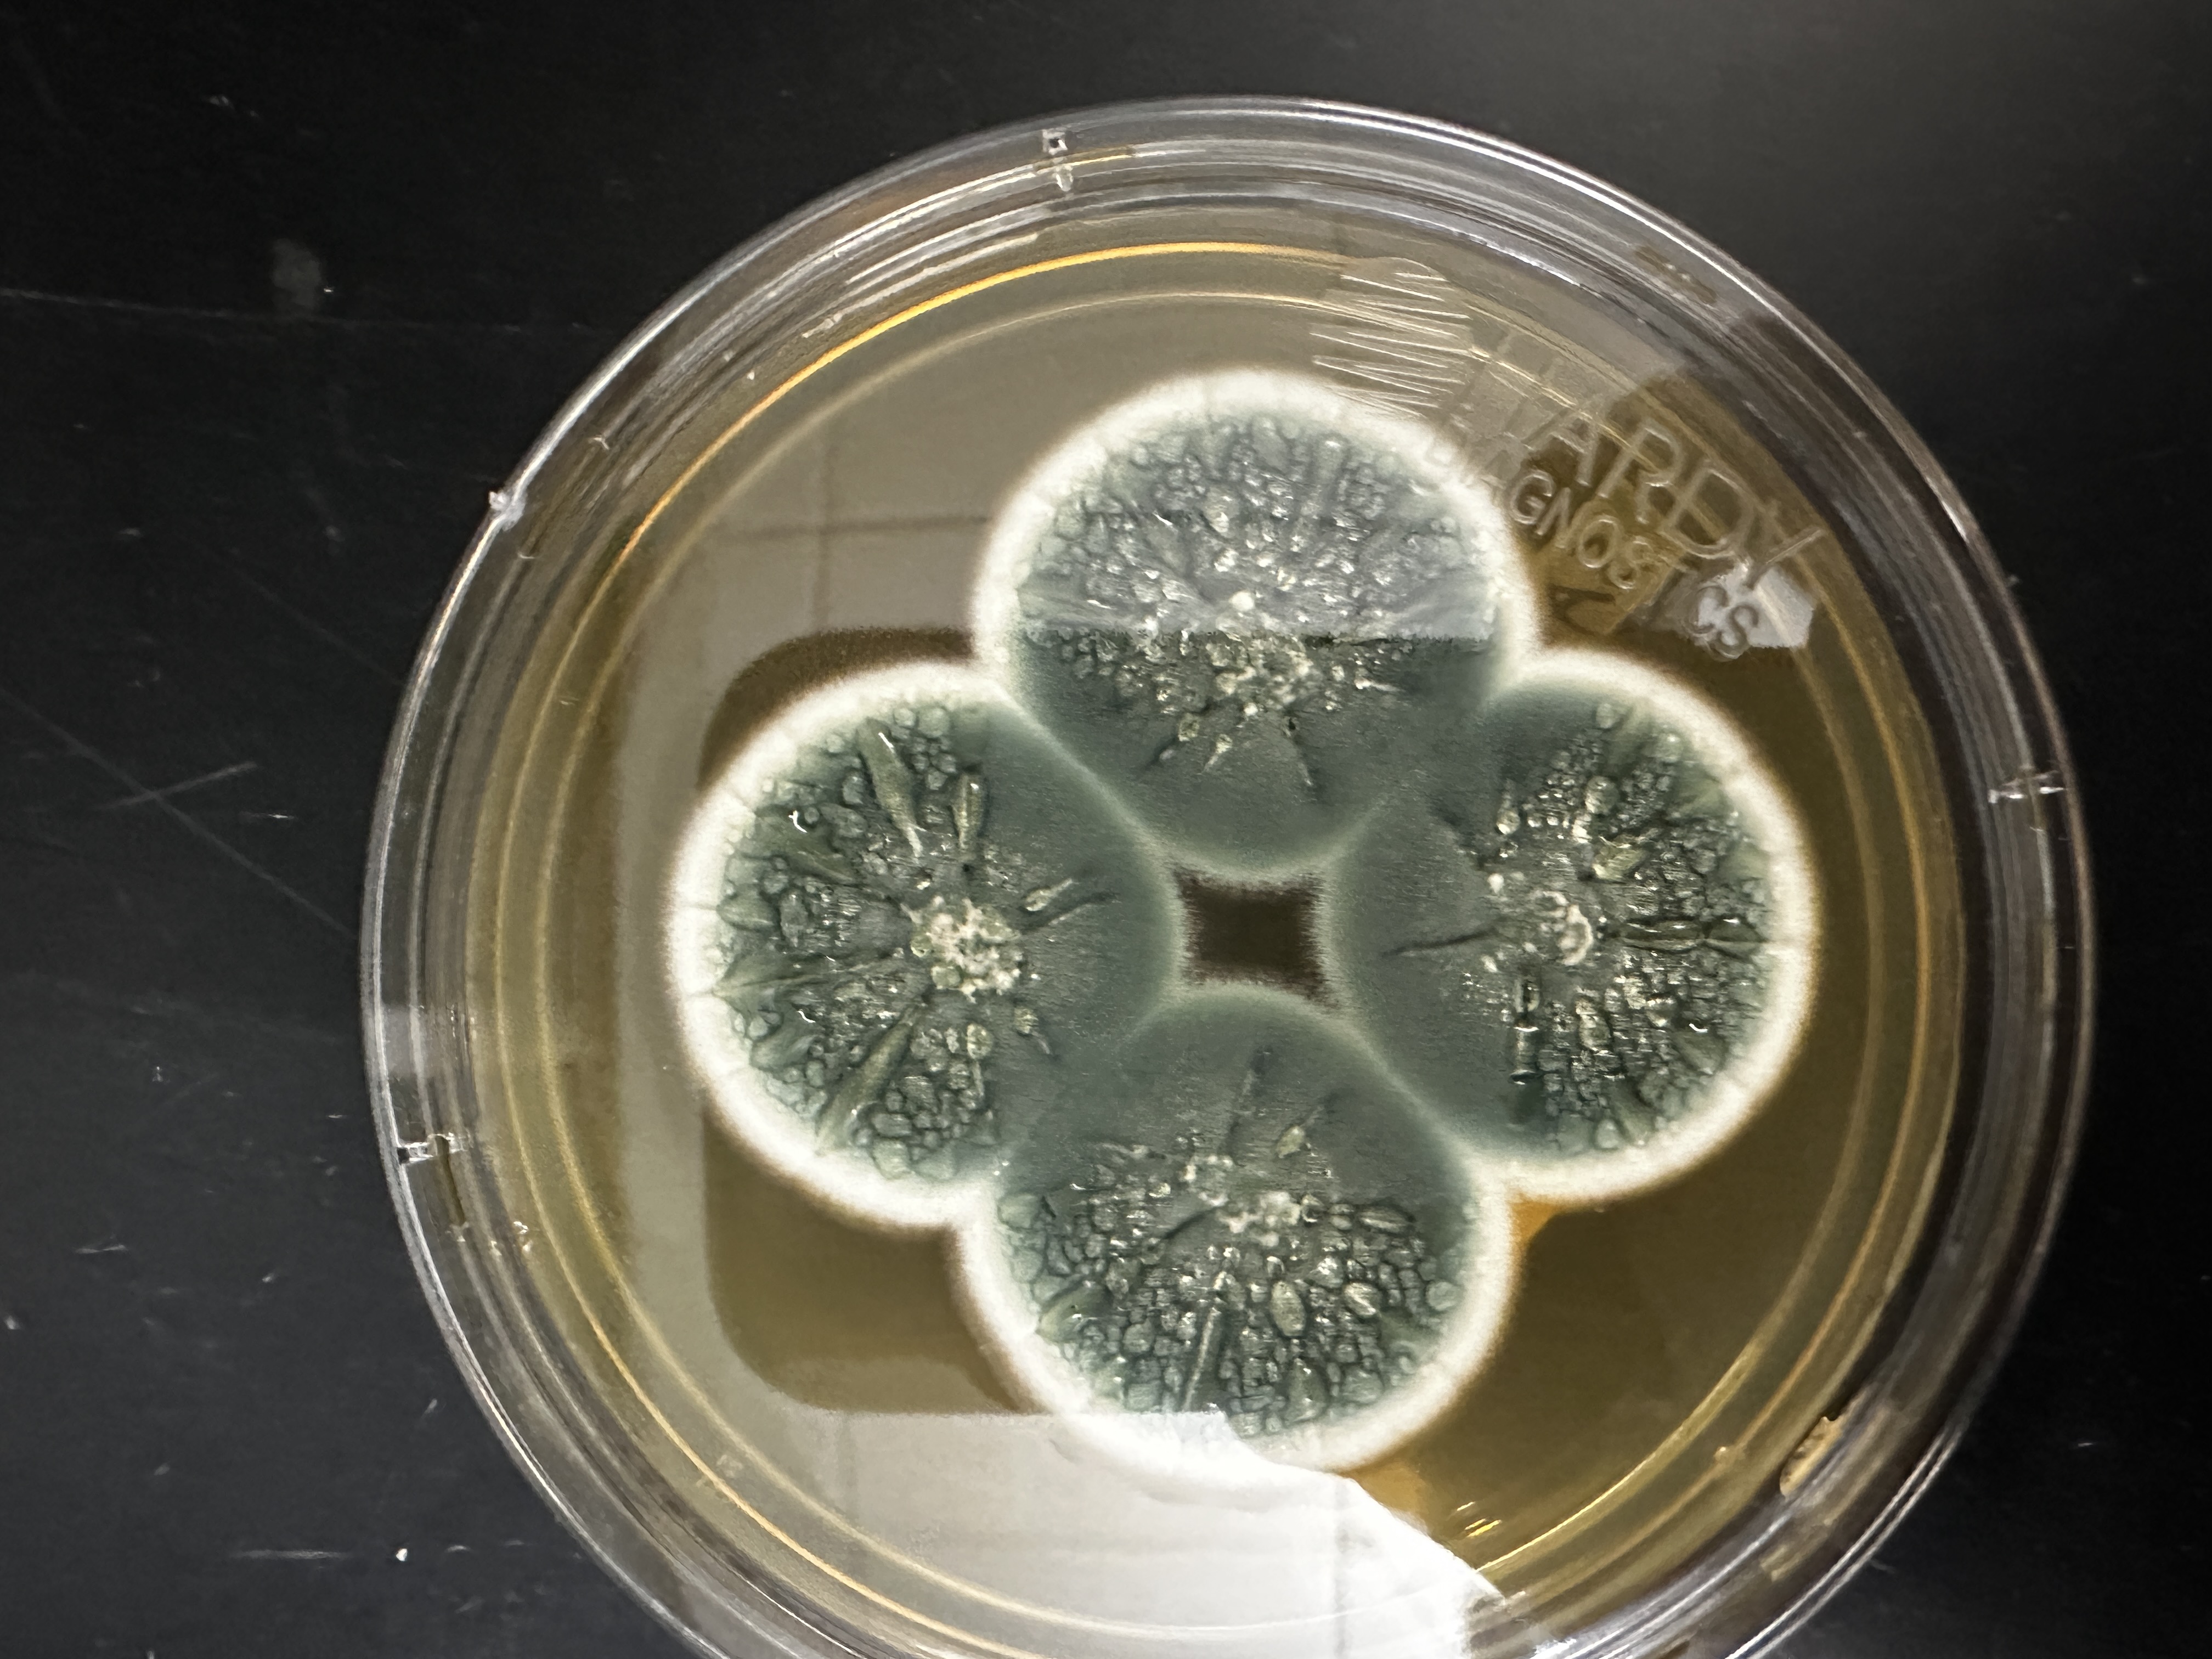
<p>Identify (Domain, Kingdom, Clade)</p>
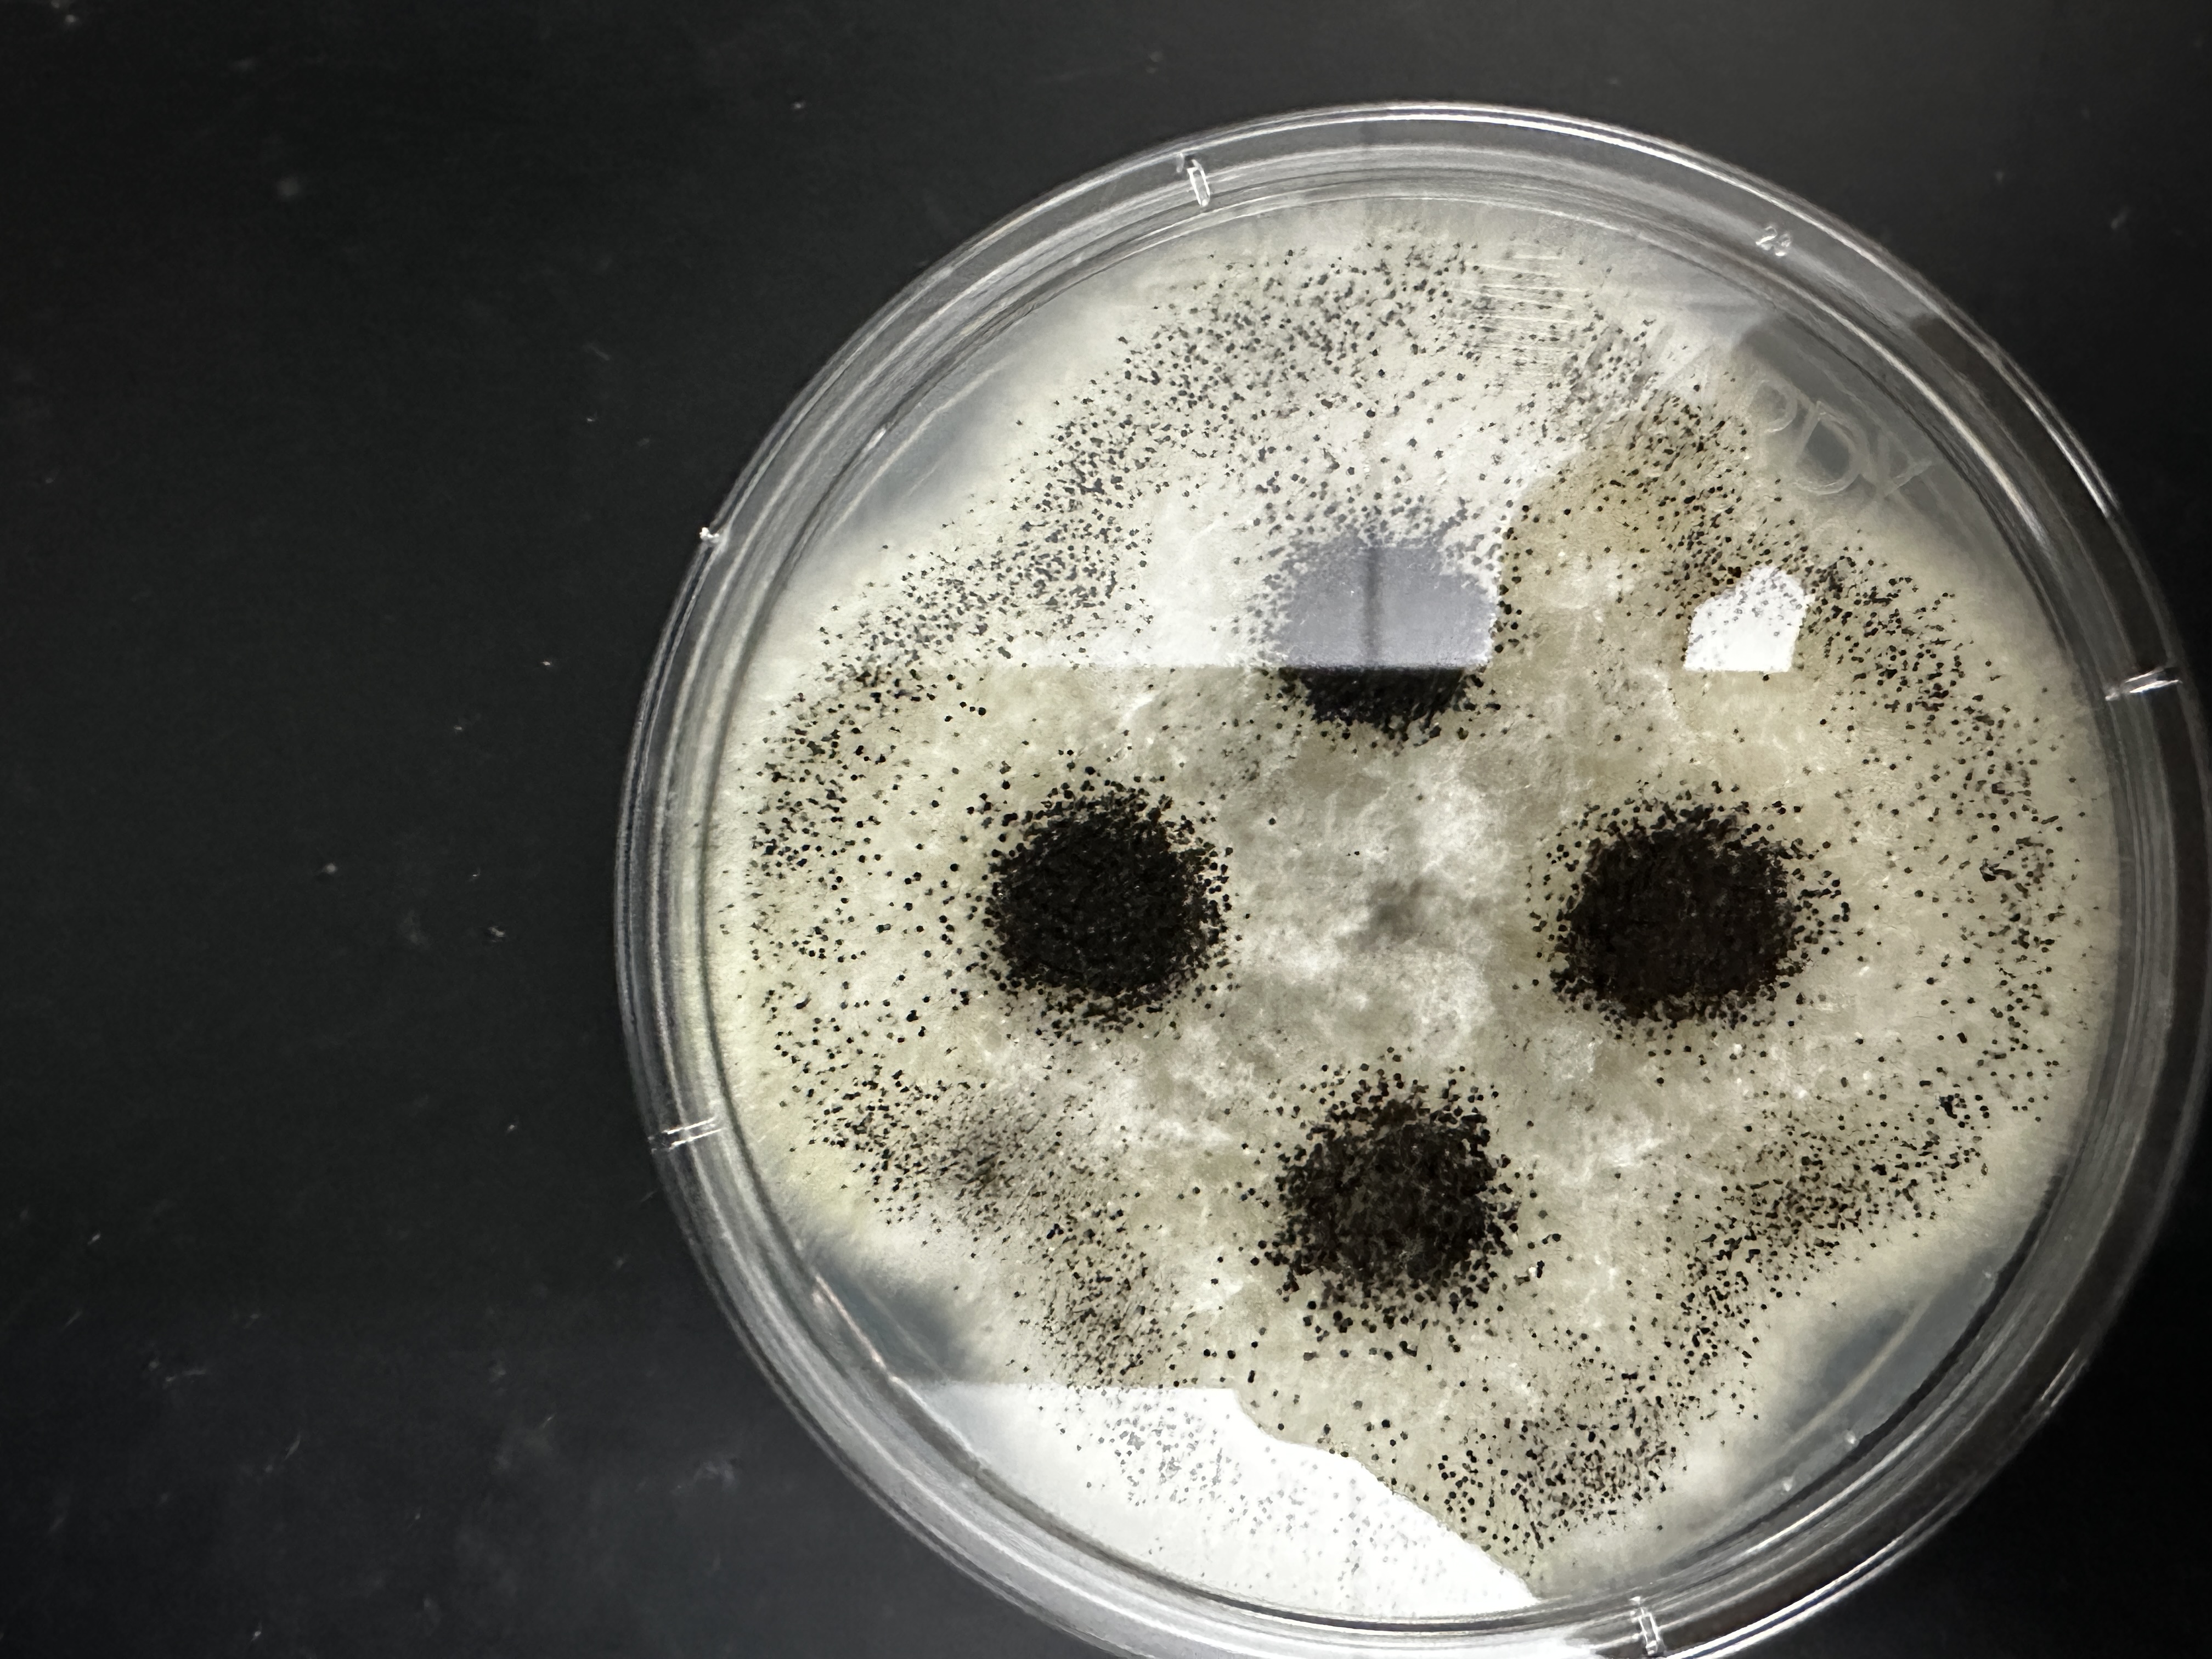
<p>Identify (Domain, Kingdom, Clade)</p>
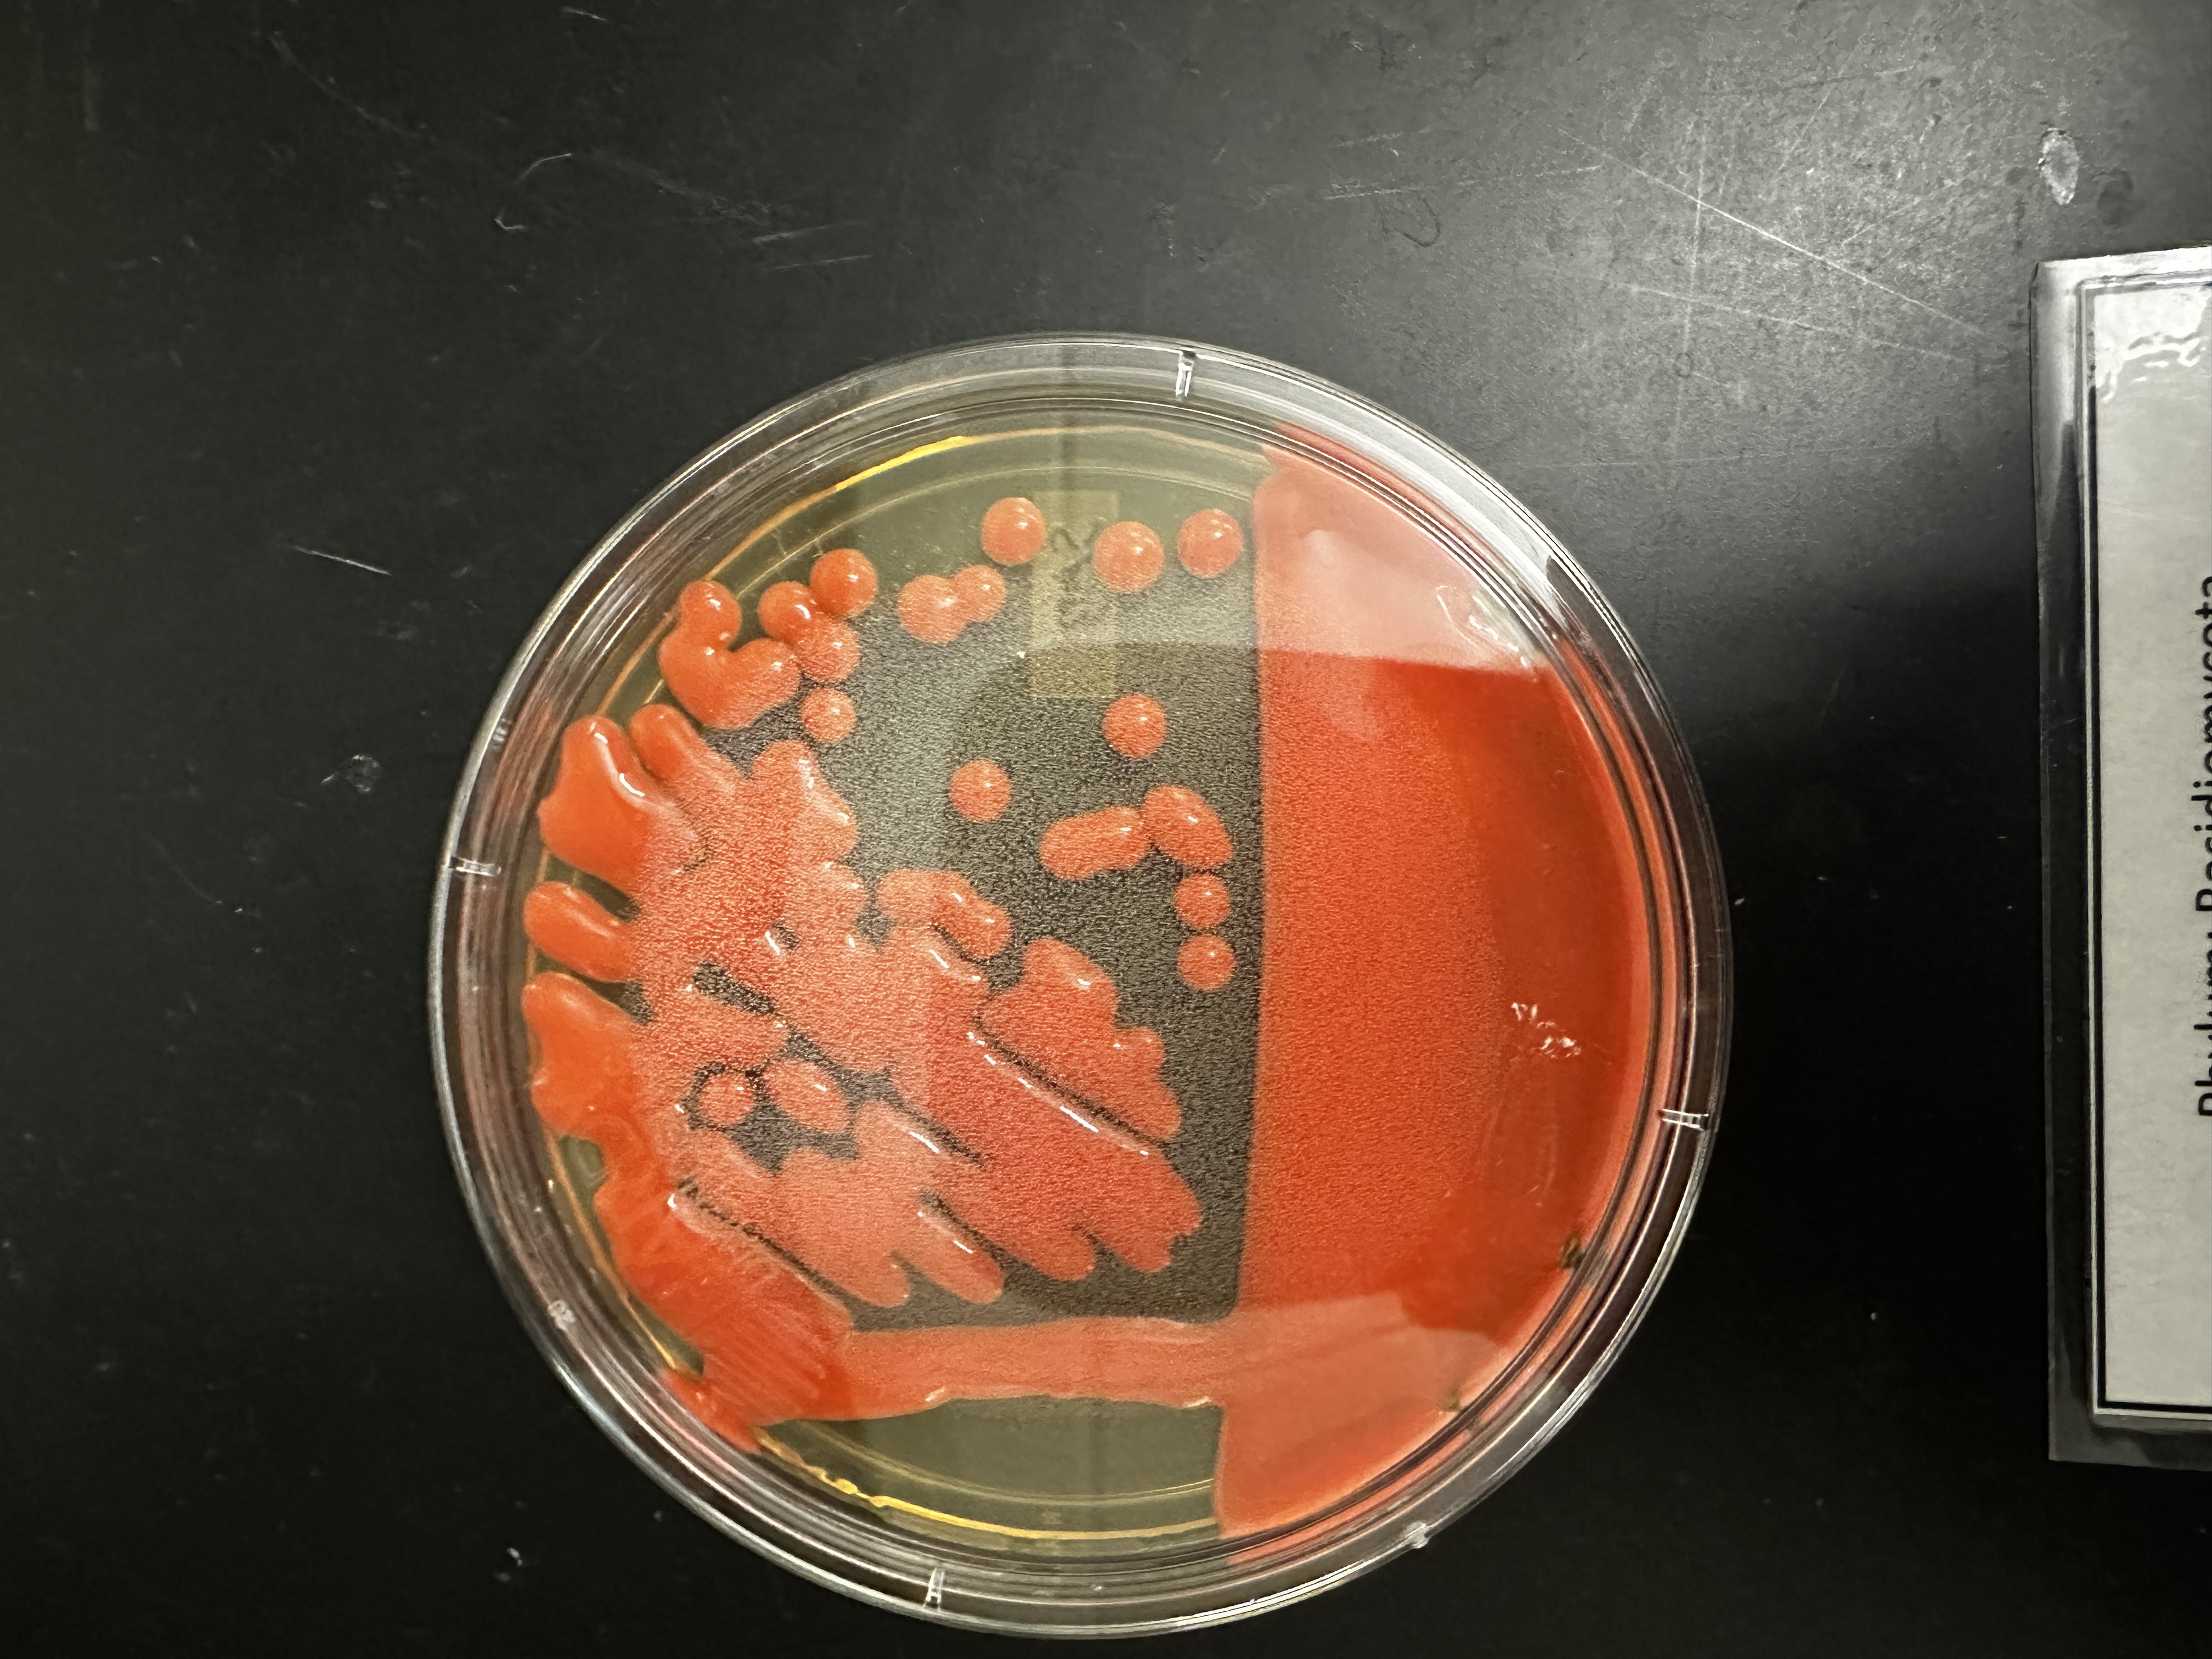
<p>Identify (Domain, Kingdom, Clade)</p>

Microorgs 2 (Fungi)
1/41
There's no tags or description
Looks like no tags are added yet.
Name | Mastery | Learn | Test | Matching | Spaced | Call with Kai |
|---|
No analytics yet
Send a link to your students to track their progress
42 Terms
What is fungi made of?
Hyphae
What is Fungi’s classification for obtaining energy
Heterotroph
Clade Mucoromycontina
Pin molds (on bread)
No phylum
Identify (Domain, Kingdom, Clade)
Domain: Eukarya
Kingdom: Fungi
Clade: Mucoromycontina


Label + Identify (Domain, Kingdom, Clade, What is it?) + Haploid or Diplod?
Sporangia
Haploid
Domain: Eukarya
Kingdom: Fungi
Clade: Mucoromycontina


Label + Identify (Domain, Kingdom, Clade, What is it?) + Haploid or Diploid
Zygospore
Diploid
Domain: Eukarya
Kingdom: Fungi
Clade: Mucoromycontina


Identify (Domain, Kingdom, Clade)
Domain: Eukarya
Kingdom: Fungi
Clade: Mucoromycontina
Clade Chytridiomycota
Flagellated spores (Unique)
Chytrids
Parasite and disease causing fungi

What is the taxonomy of the thing that causes this?
Kills amphibians
Domain: Eukarya
Kingdom: Fungi
Clade: Chytridiomycota

Identify (Domain, Kingdom, Clade)
Domain: Eukarya
Kingdom: Fungi
Clade: Chytridiomycota
Clade Ascomycota
Majority of yeasts
Also cordyceps
Cup fungi
Forms Ectomycorrhizial fungi
Have ascus (sac-like) containing ascospores.

What is the taxonomy of the thing that causes this?
Domain: Eukarya
Kingdom: Fungi
Clade: Ascomycota

Identify (Domain, Kingdom, Clade)
Domain: Eukarya
Kingdom: Fungi
Clade: Ascomycota

Identify (Domain, Kingdom, Clade)
Domain: Eukarya
Kingdom: Fungi
Clade: Ascomycota

Identify (Domain, Kingdom, Clade)
Domain: Eukarya
Kingdom: Fungi
Clade: Ascomycota

Identify (Domain, Kingdom, Clade)
Domain: Eukarya
Kingdom: Fungi
Clade: Ascomycota


Label + Identify (Domain, Kingdom, Clade)
Domain: Eukarya
Kingdom: Fungi
Clade: Ascomycota


Label (Parts & If it is haploid, diploid, dikaryotic, or multiple) + Identify (Domain, Kingdom, Clade)
Domain: Eukarya
Kingdom: Fungi
Clade: Ascomycota

Clade Basidiomycota
Mushroom, shelf, and bracket fungi
Forms ectomycorrhizal fungi
Have basidium (club-like) that contains basidia’s pores

Identify (Domain, Kingdom, Clade)
Domain: Eukarya
Kingdom: Fungi
Clade: Basidiomycota


Identify (Domain, Kingdom, Clade)
Domain: Eukarya
Kingdom: Fungi
Clade: Basidiomycota


Identify (Domain, Kingdom, Clade)
Domain: Eukarya
Kingdom: Fungi
Clade: Basidiomycota


Identify (Domain, Kingdom, Clade)
Domain: Eukarya
Kingdom: Fungi
Clade: Basidiomycota


Identify (Domain, Kingdom, Clade)
Domain: Eukarya
Kingdom: Fungi
Clade: Basidiomycota


Identify (Domain, Kingdom, Clade)
Domain: Eukarya
Kingdom: Fungi
Clade: Basidiomycota

Identify (Domain, Kingdom, Clade)
Domain: Eukarya
Kingdom: Fungi
Clade: Basidiomycota


Identify (Domain, Kingdom, Clade)
Domain: Eukarya
Kingdom: Fungi
Clade: Ascomycota


Label (Parts & If it is haploid, diploid, dikaryotic, or multiple) + Identify (Domain, Kingdom, Clade)
Domain: Eukarya
Kingdom: Fungi
Clade: Basidiomycota


Label + What is it?
Ectomycorrhizal fungi


Label + What is it?
Arbuscular mycorrhizal fungi


Label + What is it?
Lichen


Label parts


Label lifecycle

Lichens
Mutualistic symbiotic relationship
Creates a composite organism
Algae (Green Algae or Cyanobacteria) and Fungi (Absorbs nutrients, makes up majority of Lichen with hyphae)
Types:
Crustose (Grows on substrate directly don’t usually grow upwards)
Foliose (Grows on substrate directly but have lower layer, can grow upward)
Fruticose (Three dimensional growth off substrate)

Identify (Name + Type)
Lichen
Crustose

Identify (Name + Type)
Lichen
Foliose

Identify (Name + Type)
Lichen
Fruticose
Mycorrhizae
Mutualistic symbiotic relationship between fungi hyphae and plant roots
Types
Ectomychorrizae (Does not grow inside/penetrate plant cells)
Arbuscular Mycorrhizal Fungi (Grow into/penetrates root cells)
What type of spore does Chytridiomycota have?
Zoospores
What type of spore does Mucoromycontina have?
Zygospores
What type of spore does Ascomycota have?
Asci
What type of spore does Basidiomycota have?
Basidia